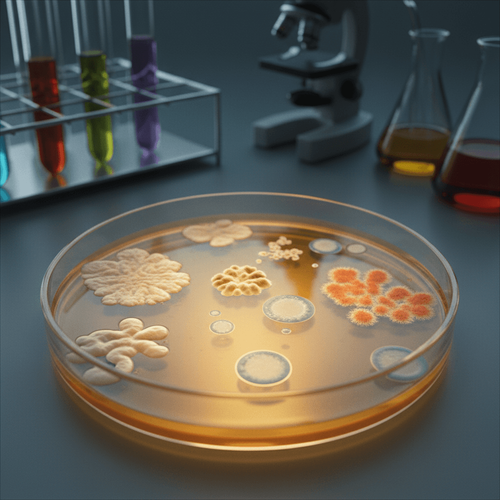
new-skin-bacteria-uncovered-what-else-is-hiding

The rise of targeted immunomodulatory therapies, like JAK inhibitors and biologics, has revolutionized dermatology. But this progress comes with a nagging concern: infection. How real is the increased risk, and how should clinicians counsel patients considering these powerful drugs? A recent meta-analysis attempts to quantify this risk, but as always, the devil is in the details.
We're not just talking about minor skin infections. These therapies can potentially increase susceptibility to serious systemic infections, opportunistic pathogens, and reactivation of latent infections like tuberculosis. For patients already dealing with the burden of chronic inflammatory skin conditions, the added anxiety is significant. Can we truly parse out the real risks from the background noise of observational data? That's what we need to address.
Clinical Key Takeaways
lightbulb
- The PivotThis meta-analysis reinforces the need for heightened vigilance regarding infection risk with JAK inhibitors and biologics, prompting a more critical look at baseline risk factors and preventative strategies.
- The DataThe meta-analysis reports a statistically significant, though potentially modest, increase in infection risk. Clinicians should scrutinize the confidence intervals and consider the potential for heterogeneity across included studies.
- The ActionImplement a thorough pre-treatment screening protocol, including assessment for latent infections, vaccination status, and patient-specific risk factors, before initiating JAK inhibitors or biologics.
Infection Risk Assessment
The question isn't whether immunosuppression increases infection risk. It's *how much* and *in whom*. Meta-analyses, while powerful tools, are only as good as the data they aggregate. This particular analysis pools data from studies with varying designs, patient populations, and definitions of infection. Therefore, interpreting the overall effect size requires careful consideration of these factors.
Specifically, what types of infections are being reported? Are we seeing a higher rate of herpes zoster reactivation, a known risk with JAK inhibitors, or are we seeing a broader spectrum of bacterial, viral, and fungal infections? The clinical implications differ significantly. Furthermore, the baseline risk of infection varies substantially between patients with atopic dermatitis and those with psoriasis, the two most common conditions for which these drugs are prescribed.
Guideline Comparison
Current guidelines from organizations such as the American Academy of Dermatology (AAD) acknowledge the increased infection risk associated with both JAK inhibitors and biologics. However, they often lack specific, evidence-based recommendations for risk stratification and preventative measures. The British Association of Dermatologists (BAD) provides a slightly more detailed algorithm, emphasizing screening for latent tuberculosis and hepatitis B before initiating therapy. This meta-analysis, while not changing the fundamental recommendations, should prompt a more rigorous application of existing guidelines.
This subtly contradicts some of the less cautious interpretations of the AAD guidelines that some clinicians might hold. The AAD guidance allows for clinician discretion and does not mandate specific testing protocols. This analysis suggests that a more standardized and proactive approach to infection screening and prevention is warranted, pushing back against a more relaxed 'wait and see' approach. Are you comfortable with the level of diligence your current practice applies?
Study Limitations
Let's be clear: this meta-analysis is not without its limitations. The included studies likely exhibit significant heterogeneity in terms of patient populations, drug dosages, and outcome definitions. The statistical methods used to adjust for these differences may not fully account for all confounding factors. Furthermore, publication bias is a real concern, as studies with negative findings (i.e., no increased infection risk) are less likely to be published. The reliance on observational data, inherent to meta-analyses of this type, introduces the potential for selection bias and confounding.
The confidence intervals reported for the overall effect size are relatively wide, indicating substantial uncertainty. While the point estimate may be statistically significant, the true effect size could be much smaller, or even clinically insignificant. Is the signal strong enough to justify a change in clinical practice, or are we simply chasing statistical noise?
Subgroup Analysis Concerns
Subgroup analyses, often conducted to explore potential differences in infection risk based on specific drugs or patient characteristics, should be interpreted with extreme caution. The statistical power of these analyses is often limited, increasing the risk of false-positive findings. Furthermore, multiple comparisons can inflate the overall type I error rate, leading to spurious associations. If the study teased out differences between specific JAK inhibitors, for instance, those results may not be reproducible.
Did the meta-analysis adequately address the potential for confounding within subgroups? For example, patients receiving higher doses of a particular drug may also have more severe disease, independently increasing their risk of infection. Disentangling these complex relationships requires sophisticated statistical modeling, which may not have been fully implemented.
Impact on Practice
While this meta-analysis doesn't necessarily warrant a wholesale revision of treatment guidelines, it does reinforce the importance of a risk-based approach to prescribing JAK inhibitors and biologics. Clinicians should engage in a thorough discussion with patients about the potential risks and benefits of these therapies, tailoring treatment decisions to individual patient circumstances. This involves assessing baseline risk factors for infection, such as age, comorbidities, and prior history of infections. A comprehensive vaccination strategy should be implemented whenever possible.
We should also consider the economic impact of increased infection risk. More infections mean more healthcare utilization, more antibiotic prescriptions, and potentially more hospitalizations. These costs need to be factored into the overall value equation when considering these relatively expensive medications. Does the clinical benefit outweigh the potential economic burden of increased infection risk? That’s a question for hospital administrators and payers to address.
Given these findings, dermatology clinics should standardize their screening protocols for patients starting JAK inhibitors and biologics. This includes detailed history taking, physical examination, and appropriate laboratory testing. Clear documentation of risk assessment and patient counseling is essential. Consider creating standardized order sets in your EMR to prompt necessary pre-treatment evaluations. Reimbursement for preventative testing, such as latent TB screening, should be proactively addressed with payers to avoid unnecessary financial burden on patients and the clinic.
LSF-8164280669 | December 2025

How to cite this article
Webb M. Jak inhibitors and biologics: weighing infection risks in dermatology. The Life Science Feed. Published January 26, 2026. Updated January 26, 2026. Accessed April 2, 2026. https://thelifesciencefeed.com/dermatology/skin-diseases-bacterial/research/jak-inhibitors-and-biologics-weighing-infection-risks-in-dermatology.
Copyright and license
© 2026 The Life Science Feed. All rights reserved. Unless otherwise indicated, all content is the property of The Life Science Feed and may not be reproduced, distributed, or transmitted in any form or by any means without prior written permission.
Fact-Checking & AI Transparency
This content was produced with the assistance of AI technology and has been rigorously reviewed and verified by our human editorial team to ensure accuracy and clinical relevance.
References
- Singh, J. A., et al. (2023). 2022 American College of Rheumatology/American Association of Hip and Knee Surgeons guideline for the perioperative management of antirheumatic medication for adults undergoing elective total hip arthroplasty or total knee arthroplasty. *Arthritis & Rheumatology*, *75*(2), 203-215.
- Fraunfelder, F. W., et al. (2021). Serious infections and hospitalization rates in patients with rheumatoid arthritis treated with tofacitinib versus tumor necrosis factor inhibitors. *Journal of Rheumatology*, *48*(3), 328-335.
- Upala, S., et al. (2016). Risk of tuberculosis associated with the use of tumor necrosis factor alpha inhibitors: A systematic review and meta-analysis. *Journal of Clinical Pharmacy and Therapeutics*, *41*(1), 5-15.